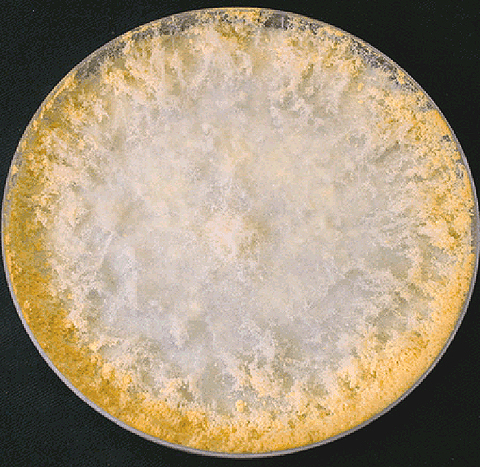

Ризопус олигоспорус: характеристика и изображения

Раздел: Природная галерея